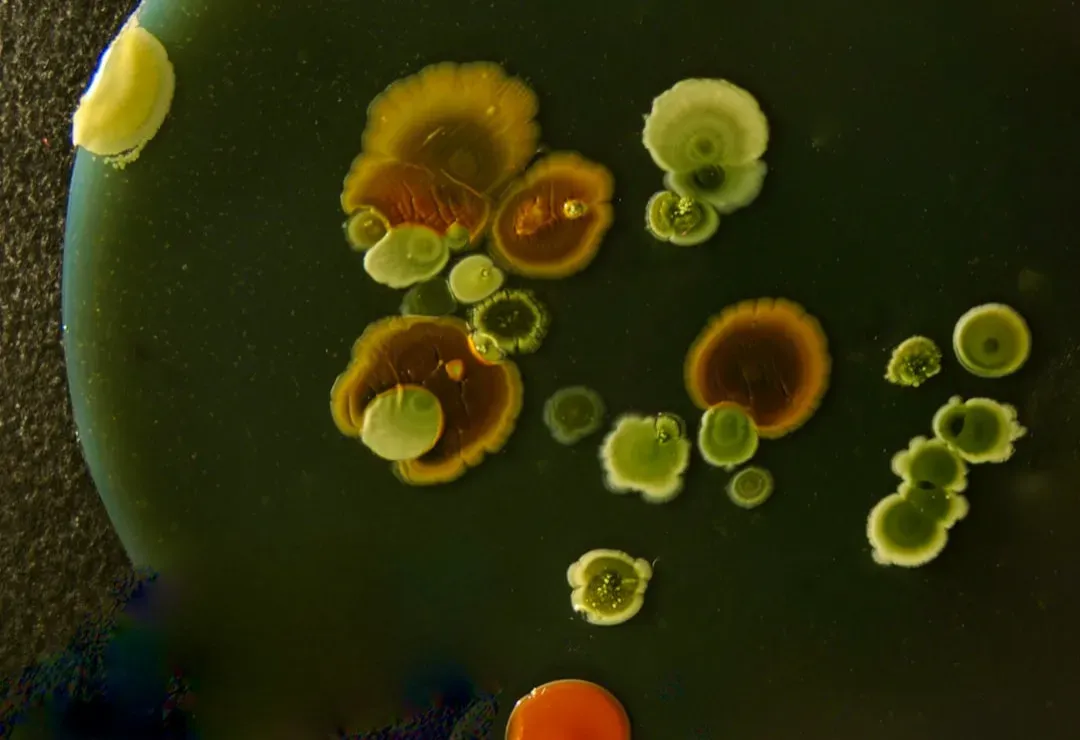
Radiation, Desiccation, and the Limits of Survival (Image Credits: Unsplash)

There’s something quietly mind-blowing about realizing that while we complain about a room being a bit too cold or too hot, there are tiny organisms out there happily living in boiling acid, crushing pressure, or deadly radiation. The more scientists look, the more they keep stumbling on life in places where, for decades, everyone assumed nothing could possibly survive. It’s like Earth has been hiding a secret cast of microscopic superheroes in the background the whole time.
I remember the first time I saw photos of a deep-sea vent community in a textbook: pale crabs, giant tube worms, and shimmering water that was actually superheated, all thriving in what looked like an underwater sci-fi volcano. I caught myself thinking, if life can pull that off here, what else might be possible out there in the universe? That’s the real punchline of these discoveries: every weird little extremophile on Earth rewrites what we think is “too extreme” for life anywhere.
Scalding Hot Springs: Microbes That Love to Boil

It feels completely against common sense that anything could enjoy water hot enough to scald skin in seconds, yet hot springs are teeming with heat-loving microbes called thermophiles and hyperthermophiles. In places like Yellowstone’s colorful pools, streaks of bright orange, yellow, and green aren’t just pretty patterns; they’re dense microbial communities doing just fine at temperatures that would ruin most proteins in ordinary cells. Some of these organisms handle temperatures close to the boiling point of water, and a few archaeal species can even tolerate water above that when it’s under pressure.
These microbes rebuild the basic machinery of life to survive the heat, using specialized proteins and membranes that don’t fall apart when things get scorching. The pigments that make those surreal colors aren’t just for show either; many help capture light for energy or protect their cells from damage. What’s wild is how much practical impact these organisms have had on us without most people noticing. A famous heat-resistant enzyme from a hot-spring microbe became a cornerstone of modern DNA technology, powering everyday genetic tests, medical diagnostics, and research labs around the world.
Deep-Sea Vents: Life Without Sunlight

Far below the ocean’s surface, where sunlight never arrives and the pressure is strong enough to crush a car, life has built entire ecosystems around cracks in the seafloor. These hydrothermal vents spew out superheated, mineral-rich water that mixes with icy deep-sea currents, creating shimmering plumes that look almost ghostly. Instead of using sunlight like plants do, the base of this food web is made of microbes that perform chemosynthesis, turning chemicals such as hydrogen sulfide into usable energy.
Around these tiny chemical factories, bizarre animals cluster: thick red-tipped tube worms, shrimp with strange eyes, ghostly white crabs, and clams stuffed with symbiotic bacteria in their tissues. Many of these creatures rely directly on their resident microbes to feed them, almost like carrying a personal farm inside their own bodies. It’s a complete biological world operating on rules that don’t care about daylight at all. Knowing that a complex ecosystem can thrive without the sun changes how scientists think about life on other worlds, especially icy moons with dark oceans hidden below their frozen shells.
Frozen Worlds: Microbes in Ice and Permafrost

When you look at a glacier or a frozen Arctic plain, it’s tempting to imagine it as lifeless, just a giant deep-freeze. But microbes have a different opinion: they’re quietly surviving in tiny films of salty water trapped between ice crystals, or in permafrost that’s been frozen for thousands of years. Some bacteria and single-celled eukaryotes have been revived from ancient ice and sediment, waking up after unimaginably long naps once the conditions warmed and water became available again.
To handle the cold, these organisms produce natural antifreeze molecules and flexible membranes that don’t shatter like brittle glass. They slow their metabolism down to a near standstill, surviving long stretches where nutrients are scarce and water is mostly locked as ice. In the polar regions, life shows up as dark streaks on snowfields, pigmented microbes that can soak up light and tolerate intense UV exposure reflecting off the ice. These frozen survivors matter for our future too: as permafrost thaws with climate change, they’re waking up and beginning to influence greenhouse gas emissions in ways researchers are still trying to fully understand.
Acid and Alkaline Extremes: Living at the Edge of pH

Acidic lakes that can corrode metal and soda lakes with alkalinity similar to household cleaners sound like terrible places to live, but acidophiles and alkaliphiles treat them like a normal neighborhood. In highly acidic mine drainage or volcanic pools rich in sulfur, specialized microbes carve out a living in conditions that would strip away most other cells’ protective layers. They maintain near-neutral conditions inside their cells while the outside world is chemically hostile, using powerful pumps to keep harmful ions out and their internal chemistry stable.
On the opposite end, some lakes are so alkaline that most organisms’ proteins would quickly misfold, yet dense blooms of microbes turn them into cloudy, colorful waters. These communities have adapted their outer membranes and enzymes to stay functional in intense pH conditions that would make human skin burn or feel slippery and damaged. Interestingly, some extremophiles in these environments are remarkable at transforming metals and minerals, which has drawn attention from industries exploring ways to clean waste or extract valuable elements more gently. It’s a strange twist that organisms once considered obscure curiosities are now potential tools for environmental repair.
Salt Saturation: Life in Briny, Almost Dry Worlds

Salt flats, hypersaline lakes, and brine pockets might look like the last stop before true dryness, but for halophiles, they’re prime real estate. These salt-loving microbes don’t just tolerate high salt levels; they actually require them to stay stable, using salt ions as part of their cellular structure. In places like deeply salty desert lakes or the most concentrated sections of marine evaporation ponds, they can turn the water vivid pink, purple, or orange with their pigments.
To survive conditions that would dehydrate most cells instantly, these organisms pack themselves with compatible solutes or adjust their internal salt content to match the outside environment. Some halophiles even use a form of light-driven energy capture with unique pigments that act a bit like solar panels. Their resilience has turned them into models for what life might look like on other planets or moons where liquid water might be extremely salty. It’s oddly poetic that when water is almost too salty to be called water at all, life still finds a way to leave a colorful signature behind.
Crushing Pressure and Hidden Depths: Life in the Subsurface

It’s easy to picture life clinging to the surface of Earth, but a surprising amount of biology may be happening kilometers below our feet and deep beneath the seafloor. In rock pores, fractures, and buried sediments, microbes known as piezophiles, or pressure-lovers, handle crushing forces and often limited nutrients for staggeringly long timescales. These ecosystems run on slow-motion chemistry, feeding on tiny trickles of energy from reactions between water, minerals, and gases rather than sunlight or fresh organic matter.
Some subseafloor communities might turn over their biomass over centuries, meaning an individual microbe could effectively sit in the same micro-pocket for a very long time. Their survival strategies can include extremely efficient DNA repair, minimal energy use, and the ability to persist in a semi-dormant state. This “deep biosphere” challenges simple ideas about what an ecosystem looks like, since there are no plants, no animals, just endless microbial negotiation with rock and water. It also raises a haunting possibility: if Earth can host such hidden life, maybe other rocky planets with underground water reservoirs are not as barren as they seem from space.
Radiation, Desiccation, and the Limits of Survival
Some of the most astonishing extremophiles don’t live in one specific extreme place, but rather are defined by what they can endure: brutal radiation, near-complete dryness, or repeated cycles of damage and repair. Certain bacteria are famous for surviving doses of ionizing radiation that would be instantly lethal to humans, thanks to extraordinary DNA repair systems and protective molecules that shield their cellular machinery. Other microbes and tiny animals like tardigrades can tolerate being dried out almost completely, then spring back when water returns, as if someone hit a biological pause button.
These resilience tricks often overlap, since organisms that can handle desiccation tend to also withstand radiation better, partly because both stresses wreck DNA and proteins in similar ways. Some extremophiles form tough spores or cysts that can ride out long journeys in dust, ice, or rock, raising questions about whether life can move between planets on natural rock fragments. While that idea is still debated, it pushes scientists to keep asking how hard you really have to try to fully kill life once it has evolved robust repair systems. In a way, these organisms represent the outer edge of life’s stubbornness, reminding us that biology is less fragile than we used to assume.
Why Extremophiles Matter for Our Future

It might be tempting to treat extremophiles as just scientific oddities, but they’re starting to play a very real role in technology, medicine, and even climate discussions. Heat-stable enzymes from thermophiles make industrial processes more efficient and less wasteful, while salt- and acid-tolerant systems inspire new ways to handle harsh industrial conditions without relying on toxic chemicals. Microbes that eat pollutants in extreme environments are being explored for cleaning up waste where traditional methods fail, including acidic mine runoff or contaminated brines.
On a bigger scale, every new extreme habitat we discover life in becomes a test case for where we should look on other worlds. I find it strangely comforting that Earth keeps surprising us like this, as if it’s politely insisting that our imagination is still too narrow. Studying extremophiles also forces us to rethink what “habitability” even means, for this planet and for others. As we send more missions to icy moons, ancient Martian rocks, and even the dark underground on Earth, the quiet message from these organisms feels clear: life is not just tough, it’s relentlessly creative in the ways it chooses to persist.



